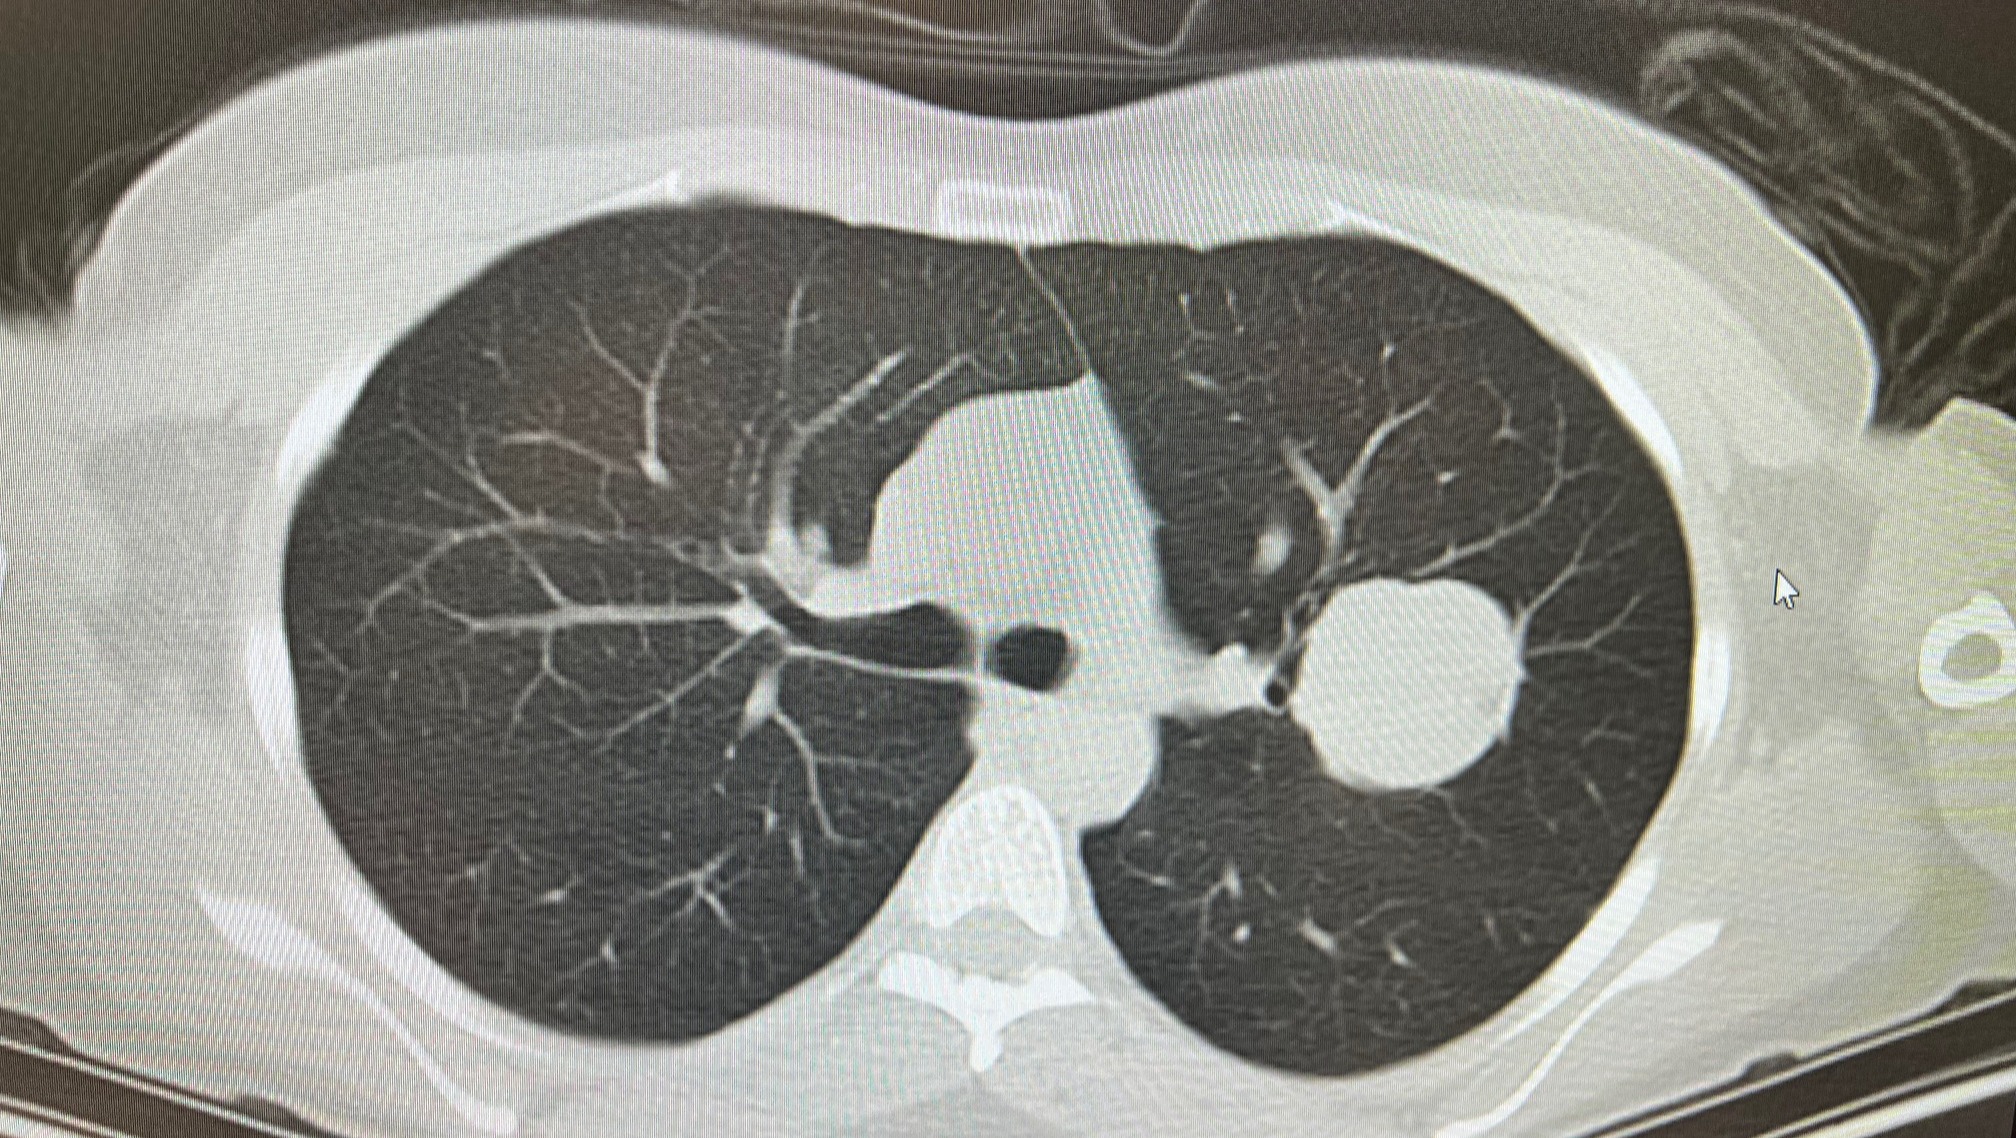

- G
Hi friends,
As many of you know, our dear friend, song angel, dog lover, project management queen and beloved community member Erin Ivey had intensive lung surgery at the beginning of this year.
Last fall she noticed chest pain, and her doctors discovered a baseball-sized tumor in her lung. The surgery to remove the tumor also removed the entire upper left lobe of her lung.
Erin has been a model patient (no surprise there!) but even still, recovery has been difficult. After three months, she is just starting to feel like herself again. She still has a ways to go, and will soon be traveling to see specialists at MD Anderson in Houston. We are organizing this GoFundMe to help alleviate the burden of her bills, medical expenses, and travel.
Over the past few months, so many of you have asked Erin how you can help and this is it!
Every contribution, no matter the size, is deeply appreciated and will go directly towards easing Erin's financial strain.
Thank you for your kindness and generosity.
Love,
Rebecca Loebe and Ali Holder
^ An actual picture of the tumor discovered in Erin's lung, which she's taken to calling her "poison apple."

Erin started working on breathing exercises to rehabilitate her lungs right away. She's made great progress, but still has a ways to go!

